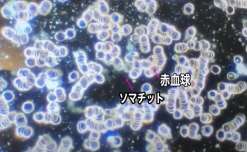

- 掲示板
ブログ更新
2017/06/17 01:13
ブログ更新しました。
宜しくお願い致します。
『関西拉麺道楽記』
関西圏のB級飯・拉麺の道楽記です。
https://blogs.yahoo.co.jp/yukio4a3
ブログランキング参加中です。⬇
https://blog.with2.net/link/?1916245
宜しくお願い致します。
『関西拉麺道楽記』
関西圏のB級飯・拉麺の道楽記です。
https://blogs.yahoo.co.jp/yukio4a3
ブログランキング参加中です。⬇
https://blog.with2.net/link/?1916245
サークルに参加すると投稿することができます
サークルに参加する- 2023/07/22 17:02落とし穴さんのハーメルンの小説「聖園ミカに憑依した話」の感想紹介を記事にしました。
クリックで拡大
ブルーアーカイブの二次創作。中編完結済で現在は番外編が更新。
聖園ミカの憑依モノというのを見かけてホイホイ釣られて読んだ作品。
(・ω・)ノ
原作のミカの人格は残っている二重人人格系憑依転生モノ。
ブルーアーカイブの人気キャラクター聖園ミカのもう一つの人格、ミカの内緒のオトモダチの"オト"に転生してミカを守ろうと奮闘するお話。
なお、自己犠牲系の主人公による約束されたミカ曇りルート。
(°▽°)
#ブログ #ハーメルン #小説紹介 #小説感想
https://huyucolorworkshop.com/hameln_mika_hyoui/ - 2023/07/22 18:38ブログを更新しました。
クリックで拡大
【メンタルエイド】
BRAND-NEW MUSIC DAYS
今回あなたの心に届けたい楽曲は
サザンオールスターズの最新曲
「盆ギリ恋歌」です。
https://showra93.com/southern-all-stars-bongiri-koiuta-lyrics-means-kousatsu-7596
サザンオールスターズのデビュー45周年を
記念して発表された楽曲第1弾!
「韻踏み遊び」や「難解な言葉」が
溢れ全体を通して「意味不明」ながらも
印象的な歌詞の意味を考察!
筆者独自の視点から
この歌が伝えたい想いの本質をお伝えします。
#ブログ更新中プロフィールからgo
#今日の一曲 #オススメの曲 #歌詞考察
#サザンオールスターズ #盆ギリ恋歌
#歌詞 #意味 #考察 #本質 #真意
#盆義理 #お盆 #シェア拡散お願いします
#サザンオールスターズ好きと繋がりたい - 2023/07/22 19:07ブログを更新しました!
ヒーリングのことや不思議な話などを書いておりますので、興味がおありでしたらご覧くださいm(_ _)m
『本当の自分』なんてモノを探し歩けば心は迷子になる
https://orion12.hatenablog.com/entry/2023/07/22/190000 - 2023/07/22 19:51
- 2023/07/23 11:12ブログ更新しました。
今回は「ライティングの3原則」についてまとめてみました。
記事を書く前に決めておく3つの決め事について解説しました。
気になる方は是非、読んでみてくださいね。
https://www.blog-weapon.info/2023/07/blog-post_23.html - 2023/07/23 11:46信号機のプラモデルにLEDを仕込んで、それをマイコンボードで制御してみました。
クリックで拡大
ただ点灯する信号機のおもちゃはありますが、今回は本格派。
ちゃんと歩行者用信号が点滅してから車両用が黄色に変わって...
という感じですべてプログラミングしています。
開封から、LEDを仕込む組み立てのところ、制御のプログラミングに関してもすべて動画にしておりますので、
興味がございましたら是非ご覧ください。
https://www.hobbyhappyblog.jp/signal-movie-up - 2023/07/23 12:10一生懸命仕事をするけど
クリックで拡大
・周りの人と比べて落ち込む
・他人の目や評価が気になる
そんな自分に疲れませんか?
過去の自分もそうでした。
その経験から心も体も解放する
「5つの習慣」をご紹介します。
#転職活動
#GOODJOBLOG
https://kazutomo-nagasawa.com/?p=3764 - 2023/07/23 12:28ブログ更新しました。
今回は「ライバル群から抜け出す4つの戦略」についてまとめてみました。
気になった方は是非、よんでみてくださいね。
https://www.blogwriter-blog.info/2023/07/blog-post.html - 2023/07/23 15:14crowdさんのハーメルンの小説「エロゲ世界のサブヒロインにTS転生したやつはファンディスクでがっつりヤってる事を知らない」の感想紹介を記事にしました。
クリックで拡大
ハーメルンでランキングでたまに見かけるTS転生ラブコメ。現代ファンタジー風味で勘違いモノな味付け。
(・ω・)ノ
ゲーム世界に転生した主人公の凛音ちゃんはゲームの世界では攻略対象外だけど人気が高いゲーム主人公の幼馴染の女の子…と本人は思っているが、実はファンディスクで攻略キャラに昇格。
凛音ちゃんが主人公君を他の攻略キャラの女の子と接近させようとするも実は自分が好感度をガンガン稼いでしまっているお話。
(/・ω・)/ワーイ
#ブログ #ハーメルン #小説紹介 #小説感想
https://huyucolorworkshop.com/hameln_ts_sab_fan/ - 2023/07/23 19:02ブログを更新しました!
ヒーリングのことや不思議な話などを書いておりますので、興味がおありでしたらご覧くださいm(_ _)m
「チカラがあれば因縁は消せるのだ!」とかいう傲慢
https://orion12.hatenablog.com/entry/2023/07/23/190000 - 2023/07/23 21:21ブログ更新しました。
クリックで拡大
パソコンフリーズとの戦い!ポンコツノートパソコンの意外な活躍? カロリー集計 7月 22日の分?
https://cosmos196102.blog.fc2.com/blog-entry-1249.html - 2023/07/23 23:11ブログ更新しました。
心が楽になる在職中にすべき習慣~体を壊した時の上手な辞め方~「度一切苦厄」https://blog.goo.ne.jp/zenpsychological/e/27abed757b11b3da56a492f2ba5a8c5d?fm=rss - 2023/07/24 01:11こんにちは、オトナ帝国です。
クリックで拡大
2023/7/20発売の信長の野望新生PKの速報レビューをまとめました。
steamでの評価は「やや不評」なんどけど、、個人的には結構好きです!
少し攻城戦が守備有利すぎるところあるけど、リアル路線でいいと思うし、直談もいいし、、今のところ織田家プレイでのイベント回収はいい感じに進んでます!!
https://otona-teikoku.com/wp/noterss/n4ed8d10adf47/ - 2023/07/24 12:12仕事でつい焦ってミスをしてしまう。
クリックで拡大
そんな経験ありませんか?
これが頻繁に起きる人。
実は共通する「5つの特徴」があります。
そこをクリアにして「ゆとり」を生む思考。
クールに笑顔で仕事ができますように。
#転職活動
#GOODJOBLOG
https://kazutomo-nagasawa.com/?p=13965 - 2023/07/24 15:13
- 2023/07/24 16:30ブログ更新しました。
クリックで拡大
バルコニーに広がる果物の種たち? カロリー集計 7月 23日の分?
https://cosmos196102.blog.fc2.com/blog-entry-1250.html - 2023/07/24 17:19ADONISさんのやる夫スレ作品「マドカが宇宙勝利を目指した結果」の感想紹介を記事にしました。
クリックで拡大
古代スタートで転生者で根源接続者なまどかが捕食遊星ヴェルバーや外宇宙からの侵略に備えるために南極に機械人文明を作って宇宙勝利を目指すお話。
(・ω・)ノ
オリジナルSF文明が楽しいFateシリーズの二次創作。
分類としては多重クロスモノになるかなと。
やる夫まとめくすさんが今作をまとめてくれているのを見かけて、名前から興味を持って読んでみたらシムシティしたり架空文明を育成したりと楽しかったです。
(*´ー`*)
#ブログ #やる夫
https://huyucolorworkshop.com/yaruo_madoka_spacev/ - 2023/07/24 17:39
- 2023/07/24 19:00ブログを更新しました!
ヒーリングのことや不思議な話などを書いておりますので、興味がおありでしたらご覧くださいm(_ _)m
心のバランスとジブンガーZ
https://orion12.hatenablog.com/entry/2023/07/24/190000 - 2023/07/25 06:49【郷土玩具の杜】
クリックで拡大
懐かしい郷土玩具のブログ更新しました。
今回は佐野市朝日森天満宮の「鷽張り子」をご紹介。
お人形の写真を見てほっこりして頂けたら幸いです?
https://folktoys.blog.fc2.com/blog-entry-381.html

Googleでログイン
Googleでログイン